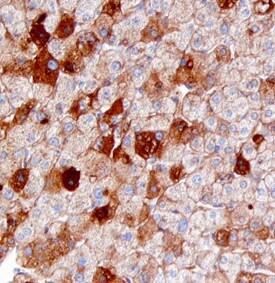
SAA4 Antibody in Immunohistochemistry (Paraffin) (IHC (P))

Search
Invitrogen
SAA4 Polyclonal Antibody
{{$productOrderCtrl.translations['antibody.pdp.commerceCard.promotion.promotions']}}
{{$productOrderCtrl.translations['antibody.pdp.commerceCard.promotion.viewpromo']}}
{{$productOrderCtrl.translations['antibody.pdp.commerceCard.promotion.promocode']}}: {{promo.promoCode}} {{promo.promoTitle}} {{promo.promoDescription}}. {{$productOrderCtrl.translations['antibody.pdp.commerceCard.promotion.learnmore']}}
图: 1 / 1
SAA4 Antibody (PA5-47545) in IHC (P)

产品信息
PA5-47545
种属反应
宿主/亚型
分类
类型
抗原
偶联物
形式
浓度
规格
纯化类型
保存液
内含物
保存条件
运输条件
RRID
产品详细信息
In direct ELISAs, less than 20% cross-reactivity with recombinant mouse Serum Amyloid A4 is observed and less than 5% cross-reactivity with recombinant human (rh) Serum Amyloid A1 and rhSerum Amyloid A2 is observed.
Reconstitute at 0.2 mg/mL in sterile PBS.
靶标信息
Serum Amyloid A4 (SAA4) is a gene that encodes one of the constitutively expressed serum amyloid proteins. Located on chromosome 11, SAA4 is part of the serum amyloid A (SAA) superfamily, which includes other highly homologous genes like SAA1, SAA2, and SAA3. Unlike its counterparts, SAA4 is not an acute-phase reactant but is persistently expressed across different tissues, including plasma, where it associates with high-density lipoprotein (HDL). SAA4 is involved in lipid metabolism and inflammatory responses, albeit not directly induced by inflammatory stimuli like other SAA proteins. It appears as multiple isoforms, some of which may be glycosylated. Recent studies have shown that SAA4 expression encompasses a broad spectrum of physiological conditions and may serve as a marker in diseases involving chronic inflammation and persistent pathological states such as neovascular age-related macular degeneration. The gene's constitutive expression pattern suggests its fundamental role in maintaining homeostasis rather than responding dynamically to acute inflammatory challenges.
仅用于科研。不用于诊断过程。未经明确授权不得转售。
篇参考文献 (0)
生物信息学
蛋白别名: C-SAA; Constitutively expressed serum amyloid A protein; SAA4; Serum amyloid A-4 protein; unnamed protein product
基因别名: C-SAA; CSAA; SAA4
UniProt ID: (Human) P35542
Entrez Gene ID: (Human) 6291